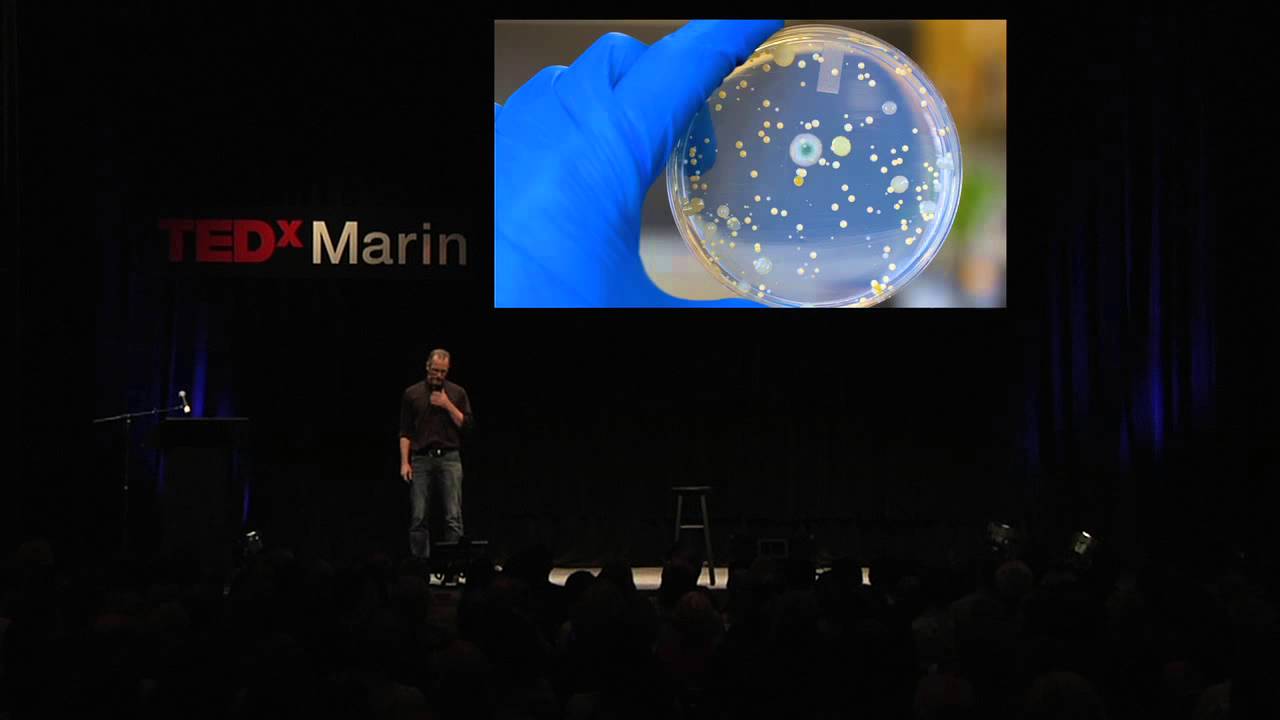
The Dark Side of the Double Helix: Andrew Hessel at TEDx Marin 2012

[Applause] I was asked in the uh last talk to tell you some of the work we're doing on synthetic life sort of the interface between the computer world and the biological world uh we reported our first uh preliminary uh results uh the proof of concept uh last April uh in science and how did we get here so we we've had sort of like 34 years now of reading the genetic code and when we read that genetic code in my view we're digitizing biology so from the first virus in uh 77 to the first syn uh
first uh bacterial genome that we did in 1995 the first human genome in 2000 all that gets encoded into the ones and zeros in the computer and our challenge for so many reasons of understanding this information uh proving biological Concepts getting down to minimal cells Etc has been to now try and go in the other direction and as soon as we made the decision uh 15 years ago to try and get to synthetic life there were two major problems first could we synthesize DNA at the size and the accuracy needed uh to get to biological
self-replicating l life and the other challenge was even if we made this DNA uh could we Boot It Up In A Cell and have it be biologically active so the problem at this field is DNA synthesis is pretty crappy the machines that make DNA uh make errors it's an N minus one situation with the longer the oligonucleotide the more errors so in this study in in 2003 that was done with my colleagues ham Smith and cly Hutchinson uh the Co directors of this program with me we made a genome uh of a small virus FX
174 and with new methods for error correcting uh these synthetic uh DNA errors the exciting stage we took this 5,000 letter molecule and injected it into eoli eoli recognized the synthetic DNA and started manufacturing the viral proteins those proteins self- assembled made the virus and we could detect it by these clear plaques on the plate because the virus showed its gratitude by killing the cells that made it uh it's somewhat like Graduate School uh so we call this a situation where the software builds its own Hardware all we did was chemically make the software put
it in a cell the cell synthesiz the virus now we didn't want to make a virus we actually wanted to make a complete bacterial genome so the second genome that we did in history was this species micoplasma genitalium it has the smallest Genome of a self-replicating organism has on the order of about 500 genes so we spent years trying to see which genes we could eliminate to get to minimal life but we decided that the complexity of making the DNA would be the hard part so we chose the smallest genome we knew because we could
make viral siiz pieces accurately that we could make lots of those and try and put those together to make the bacterial chromosome so we started with these cassettes on the order of viruses 5 to 7,000 letters and we set up a process for assembling those in stages making larger and larger pieces sort of looks like a basketball playoff at each stage we would take the DNA we' clone it in a coli make a lot of it and sequence it for validation and then take those pieces and assemble in the next stage to make the next
larger pieces it was very slow painstaking work the problem was when we got over a 100,000 letters in size eoli wasn't too happy taking these really large pieces of DNA so we looked around for some different systems we'd been looking at uh self-correction and self asssembly of DNA this is an organism dakus radiodurans that can take three million RADS of radiation and not be killed its chromosome gets blown apart as you can see in the top panel but after 12 to 24 hours it stitches its genome back together exactly as it was before and it
starts replicating again we have lots of organisms on this planet that can take these huge doses of radiation and now we have uh these organisms uh circulating in near space uh from flushing the commodes on the space station um something they stop doing uh it turns out brewer's yeast has the same remarkable abilities of reassembling DNA and we found by simply putting these large synthetic pieces together designed so they overlap with a synthetic yeast Center miror so the big difference between the procariotas turns out to be the Cent miror that allows them to grow in
the eukaryotic nucleus and we just inject these into yeast and yeast automatically assembled these into the complete bacterial genome so this is what we reported in 2008 it was the first complete bacterial genome uh that was synthesized but the problem was we couldn't Boot It Up This is an extremely slow growing organism uh and through these process of improving the chemistry uh for example Dan Gibson developed the single pot reaction we put in three enzymes at a single temperature we just throw in the small pieces of DNA with the right design and they assemble into
larger pieces we demonstrated this recently by synthesizing uh the mouse mitochondrial genome using this one pot reaction uh soon there'll be kits available and uh hopefully uh in the not too distant future robots to do this without human intervention because now we can go right from the digital code in the computer to these assemblages uh and possibly a right into biology so how do we boot up a synthetic chromosome so we had teams working in parallel on this uh and uh this I think is one of the most profound studies we published where by swapping
out the genetic code in a Cell we completely converted one species into another and because this is so important let me walk you through that so there's two micoplasma species that we use mides we isolated the chromosome from it we treated it harshly to remove any proteins because for synthesis we wanted to prove you could just work with naked DNA uh we added a couple extra genes to that chromosome so it had turn cells bright blue and so we could select for it and we injected this into a second uh micoplasma species uh capricolum these
are about the same distance apart as human and mice in terms of a genetic code and we have this very sophisticated movie to show you what we think uh happened so we injected the new chromosome into the cell and now briefly we have a capricolum cell with two sets of instructions as with the viral DNA the new DNA started to be read and some of the early proteins produced were restriction enzymes this is what my colleague ham Smith discovered and got the Nobel Prize for in 1978 that's allowed this whole field to go forward we
think these enzymes recognize the parent chromosome in the cell as foreign DNA and chewed it up so now we have a cell of one species a cytoplasma of the capricolum and the genetic instructions from mides in a very short while we had these bright blue cells and when we interrogated them all the capricolum proteins were gone replacing completely everything with the new driven by the new genetic instructions that made mides proteins so simply by swapping out the software we converted one species into another uh many people wish you could do this with a computer that
you could put a uh a piece of software and a PC and turn it into a Macintosh or that that would be a commercial hit I'm sure uh so we now had a model that would work for transplantation and to test this because we are now assembling the genomes in yeast we had a new problem we had to get the bacterial chromosome out out of a UK carot and Transplant it back into a bacteria uh and so we developed techniques to clone complete bacterial genomes in yeast just by adding the synthetic yeast centromere uh and
these genomes seem to be stably maintained so now we had a system for testing can we take the bacteria chromosome out of the UK carot and Transplant it into another bacteria and we ran into a major problem it it didn't work uh this took us about two years of 25 people to solve this and it turned out to be these same restriction enzymes and processing of the DNA when we did the initial transplant experiments taking the DNA out of the mes cells turns out that DNA was methylated and that actually protected it from the restriction
enzymes in the cell uh but why its enzymes could work on the other DNA so we found if we isolated all the Restriction enzyme genes and the methylases and methylated the DNA uh then we could transplant that chromosome and make the new species and we ultimately proved it by removing the Restriction enzyme genes from the recipient cell and then we could just use naked unmethylated DNA so at this stage we're totally confident that it would work I made predictions that we'd have it in a short period of time uh and we ran into another problem
uh before we get to this public application we had one error out of over a million letters in genetic code that prevented the synthetic uh chromosome from being booted up we actually had to develop new biological software for decoding our synthetic DNA uh and finally we found a single letter missing out of an essential Gene once we corrected that we were then able to transplant the completely synthesized mes genome so we use these new synthesis techniques uh to go back and synthesize the complete chromosome very quickly just starting with the digital code in the computer
so this is the first cell that actually has as its parent its genetic parent the computer and to prove this because we wanted to make sure we couldn't get into troubles with contamination of a single molecule of DNA we've learned various ways to Watermark the DNA inserting things in the genetic code in fact the Top Line here and if you had uh maybe somebody in the audience were some of the ones that solved this is we had a code within the genetic code uh that gave another code and if you decoded that you could actually
read in the English language uh various things that we wrote in the genetic code including the the names of 46 scientists that contributed uh uh to this working and you can see we added a few quotations from the literature uh one from James Joyce you think you get away with anything uh he's dead um his estate called and said you use that quotation without pay us uh so we ran into some problems there um and then relative to today is the quote from Richard finman that we got off the internet uh and then we got
a letter from a professor here at Caltech Mike gotle uh saying that finerman never said that um and sent us uh and we're grateful for it sent us the uh correct quote off his Blackboard um uh what I cannot uh create I do not understand so we're going back now and changing the genetic code uh to to to to to get his quote uh correct uh the other thing in that genome is a web address for people that deconvoluted the information could send an email address so this is the first species on the planet to
have its own website uh built in to its genetic code so in the order of what you heard today this is a fairly complex machine these are uh all the genes uh uh the instructions for making the species it's not a very interesting species but this is a proof of concept we now know it works we have the control experiment and we think that now we're limited only by our imagination these are actually pictures of the cell it's gone through over a billion self-replication it will go on forever if it's fed well so this new
field of synthetic genomics I I kind of likened to the electronics Industry in the 40s and 50s where there was only a few handfuls of components for design of everything we have now with Biology currently just from our Discovery from our ocean Voyage we have over 40 million genes in the data datase I view these as the design components of the future within a decade that number will probably be on the order of 200 million we're not short of design features we actually have software synthetic genomics for designing software for Designing new cells and new
species so this is an era now that these preliminary first experiments have worked that tell us anything uh is possible uh going forward in fact we have to use what we've called combinatorial genomics to put these together in a robotic fashion because there's not enough scientists given every scientist on the planet working on even the 40 million genes designed to date discovered to date we can understand their function when we announced the first synthetic cell we got an immediate response from both the pope and the president uh I think that's a first in history um
and I was not invited to a barbecue I was pleased uh with that uh in um but the president asked his new bioethics commission to take this on as their first task and they just issued their report I think they did a terrific job creating a careful balance uh between Public Safety and moving science uh forward so if we look forward to this next 50 years this is going to be a very exciting era because almost anything in anybody's imagination can be designed and made as a biological unit now we're not working at the atom
scale but you can get roughly a third of all the humanties genomes within the proverbial head of a pin uh you can get 10 to the 12 of these synthetic genomes so it's a pretty small scale but we can work now by changing evolution by building on top of it simply by designing new software of life thank you very much